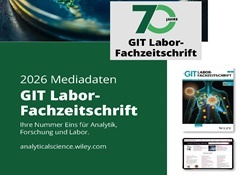
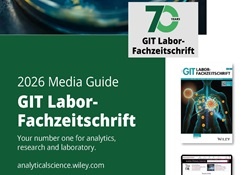

Mediadaten
Starke Medien für erfolgreiches Marketing
Das Mediennutzungsverhalten Ihrer Zielgruppe ist stetig im Wandel – nutzen Sie den veränderten Medienkonsum zu Ihrem Vorteil. Mit unseren individuell für Sie erarbeiteten Maßnahmen und Kanälen erreichen Sie Ihre Zielgruppen punktgenau, adäquat und effektiv. Entscheider informieren, Leads generieren, Marken positionieren, Image aufbauen, Neukunden akquirieren, neue Märkte erschließen – wo immer Ihr Marketingschwerpunkt liegt, unsere Media-Beraterinnen und -Berater finden in enger Zusammenarbeit mit Ihnen den effizientesten Kommunikations-Mix für Ihre Kampagne.
Profitieren Sie für Ihren Erfolg von unserer Erfahrung in den Bereichen Print, Online, Crossmedia, Corporate Publishing, Direct Marketing und Layout-Services.